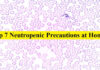
Top 7 Neutropenic Precautions at Home | Review Neutropenic Precautions review

Time is a limited resource and should be used wisely, as cost of living increases each day, survival in this super-competitive world is posing more new challenges.
Time is a variable that affects income generation, this has resulted in more people looking for ways to make extra money from home to meet the needs of their family.
Table of Contents
In this Article, We are to Discuss Ways to Make Extra Money From Home:
1. Smart Farming
It includes growing crops and rearing animals, farming is one of the most profitable ways to make extra money from home because there is a need to feed the ever-growing population. You can grow horticultural crops like vegetables in your backyard to supplement your income when you are out there at your home during free time.
Farming can also involve farm animals that will help you earn something when you sell their products. It is advisable when you want to start farming you should research different ways of farming to capitalize on your time and investment.
Note, smart farming is applicable even to people living in urban areas. For instance, you can use sucks or spoilt car tires to grow vegetables and some onions.
2. Online Writing
Online writing is a good way to earn income while you are home, online writing involves both academic and article writing you can create your timetable and invest some time in writing while you are at home.
When you want to start online writing you should find an expert to train you on how you should go about it, this will help you to organize your ideas and submit a good job.
Nowadays online writing is a good venture to invest your time in since it can earn you good income to extend that you can make it a fulltime job.
3. Online Blogs and Post
Did you know that whatever you love can make you money? I mean hobbies, be it traveling, modeling, beauty, nature, cooking, etc. you can invest time in your hobbies and earn extra money.
Blogging involves creating an article and posting them on your website. You can create your web blog or find an expert to do the job for you, but you do need to stop there, create posts and articles that will popularize your blog.
4. Tutoring
Being a tutor is one of the best ways you can earn money at home, you can start online tutoring using websites like tutor.com that will help you. Tutoring does not only involve subjects like maths, sciences, and languages but you can also tutor on skills like playing guitar, exercise, etc.
5. Selling Stuff on E-Commerce Platforms
E-commerce is one lucrative business that is gaining popularity after the introduction of the internet. You can sell your products on platforms like eBay, Amazon, and Jumia through which you can make extra money. You can also earn a small commission by selling other business products through these platforms.
6. Creating a YouTube Channel
If you still looking for answers on how to make extra money at home, YouTube platforms can help you achieve that. You can earn from marketing your skills on YouTube. Even little skills like cooking, knitting, or exercising can earn you passive income. Just create a YouTube channel and upload your video.
Ask your friends to download and share the video. As your YouTube audience continues to grow, you will start receiving some income.
7. Affiliate Marketing
There several products being sold online. You can help market the products at a commission. That requires you to have a website and register on the product site as an affiliate marketer. You are given a link and whenever a customer gets to open the link or the buy the product, you receive a certain commission. It’s that simple.
8. Online Selling
Online selling is one of the most popular ways on how to make extra money at home. For instance, you can start a business of selling second hand clothes with less than $50.
Ensure that you market your clothes through social media platforms. Through social media, you increase visibility and you get customers to buy your items.
Conclusion
There are many ways to make extra money from home but before you begin any income-generating activity be aware of losses too. Whatever you may want to invest your precious time in you must try and find experts who can help you or any other source of knowledge like the internet.